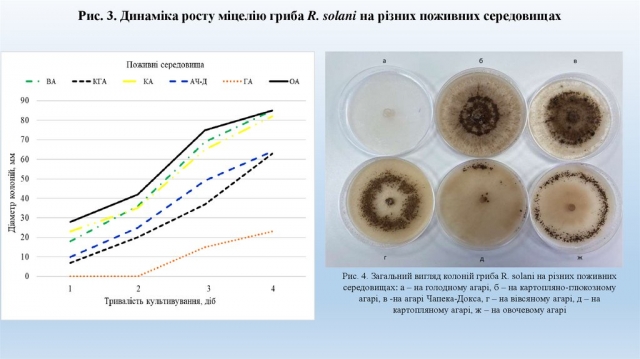
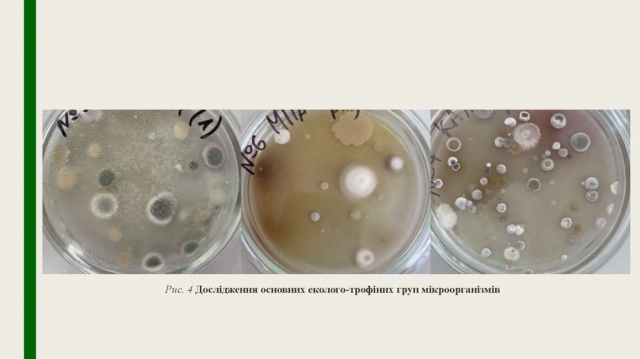

Атестація аспірантів 1, 2 та 3 року навчання факультету захисту рослин, біотехнологій та екології!
27 лютого на факультеті захисту рослин, біотехнологій та екології в очному форматі пройшла атестація аспірантів 1, 2 та 3 року навчання за освітньо-науковими програмами 091 «Біологія та біохімія», 101 «Екологія», 202 «Захист і карантин рослин», 091 «Біотехнології біологічних систем».

Комісія працювала в наступному складі: голова атестаційної комісії — декан факультету, професор Юлія Коломієць, гаранти ОНП — професор Микола Доля, професор Лілія Калачнюк, доктор біологічних наук Алла Клепко, професор Світлана Прилуцька, секретар атестаційної комісії — доцент Валерія Бондарь. На зустрічі також були присутні наукові керівники аспірантів.
Попередньо здобувачі підготували атестаційний листок аспіранта та звіт про виконання освітньо-наукової програми, який підписаний науковим керівником. Наукові керівники, в свою чергу, ретельно перевірили на достовірність подану інформацію. Юлія Василівна контролювала своєчасне оформлення атестаційних листів, звітів та витягів з протоколів засідань кафедр й вчених рад. Аспіранти 1-го року навчання розповіли про освітню складову та окреслили завдання на рік, аспіранти 2-го та 3-го року навчання доповіли про публікаційну активність та розповіли про отримані попередні експериментальні результати у вигляді презентації.


Ганна Радковська доповідала на тему «Ризоктоніоз картоплі та біологічне обґрунтування заходів контролю хвороби в Правобережному Лісостепу України», науковий керівник Мирослав Піковський. Ганна дослідила поширення ризоктоніозу картоплі в умовах Правобережного Лісостепу України за 2023 рік, підкресливши, що найбільший відсоток поширення у Волинській області Горохівського району, а найбільший відсоток розвитку в Тернопільській області Тернопільського району. Також, вона представила результати польових досліджень вивчення ефективності хімічних та біологічних фунгіцидів проти ризоктоніозу картоплі вегетаційного періоду за 2023 рік, плив протруйників бульб на урожайність картоплі та товарність бульб картоплі, провела оцінку стійкості сортів картоплі проти ризоктоніозу (дослідне поле, лабораторія ТОВ «Сингента») тощо. Ганна зазначила, що склала всі екзамени згідно з навчальним планом, опублікувала 3 тези наукових доповідей, підготувала та подала у редакцію наукового журналу 1 статтю, пройшла підвищення кваліфікації в Інституті захисту рослин НААН України.

Владислав Яненко презентував тему «Екологічна оцінка впливу експлуатації вітрових електростанцій на орнітофауну та рукокрилих в межах північно-західного Причорномор'я», науковий керівник Алла Клепко. Він коротко зупинився на кількох проведених експериментах, один з яких «Орнітофауна, рукокрилі», де розповів, що обрав стаціонарні пункти спостережень, обрав маршрути для проведення маршрутних обліків, частково дослідив період гніздування, завершив дослідження осінньої міграції, завершує дослідження зимівлі, планує виїзди для обліків весняної міграції й завершення спостережень в період гніздування. Також, Владислав підкреслив, що має 3 опубліковані наукові праці за темою дисертації у звітному році, з них: 1 стаття у наукових фахових виданнях України, 2 тези доповіді та матеріали конференцій.



Денис Мирошниченко доповів на тему «Моніторинг хвороб троянд в умовах м. Києва та обґрунтування заходів їх контролю», науковий керівник Мирослав Піковський. Денис зазначив, що лабораторні роботи проводив на базі проблемної науково-дослідної лабораторії «Мікології і фітопатології» та інших лабораторіях НУБіП України, а польові (вегетаційні) — в умовах навчально-наукових підрозділів київського територіального центру НУБіП України, ботанічних садах м. Києва. Він представив таблиці з динамікою розвитку борошнистої роси, чорної плямистості, розвитку іржі, сірої гнилі троянд, ураження сортів чайно-гібридних троянд чорною плямистістю, ураження чорною плямистістю сортів троянд групи флорибунда, детально зупинився на ефективності застосування фунгіцидів проти хвороб троянд.



Ольга Крушельницька представила тему «Особливості рослинно-мікробних взаємодій Caucus carota з мікроміцетами Glomus та Trichoderma», науковий керівник Ярослав Чабанюк. Ольга зазначила, що для проведення дослідження використовувались музейні штами Інституту Агробіології, а саме Trichoderma harzianum eko/101 та Trichoderma viride eko/103. Ольга презентувала таблиці з відсотком приросту біомаси бадилля моркви за дії різних штамів Trichoderma та їх спільної дії (від контролю), відсоток приросту біомаси коренеплоду моркви за дії різних штамів Trichoderma та їх спільної дії (від контролю), динаміку кількості мікроорганізмів у ризосфері ґрунту моркви сорту Віта Лонга за дії мікроміцетів Trichoderma, дослідження основних еколого-трофічних груп мікроорганізмів, мікроскопію мікроорганізмів ризосфери ґрунту моркви.

Слід зазначити, що комісія атестувала аспірантів та здобувачів ступеня доктора філософії лише за умови повного виконання поставлених завдань відповідного періоду підготовки згідно з індивідуальним планом. Аспіранти, які були сьогодні відсутні, матимуть змогу приєднатися онлайн на повторну атестацію 5 березня, о 13:10.


Бажаємо аспірантам факультету захисту рослин, біотехнологій та екології наполегливості та натхнення у процесі написання дисертації!
Наталія Батрак